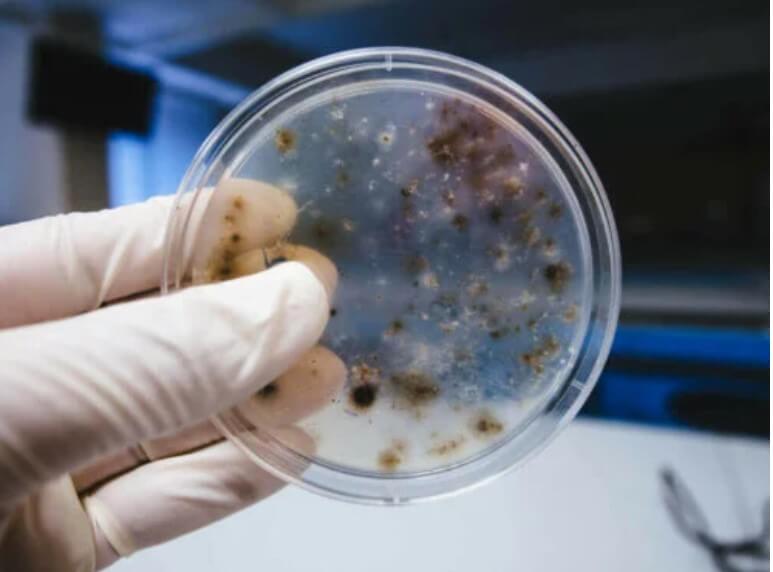
μικρόβια σε πείραμα

Μικρόβια: Τι είναι και πού βρίσκονται συνήθως;

Αναρωτηθήκατε ποτέ ποια είναι τα μικρόβια;
Η λέξη «μικρόβιο» έχει διαφορετικές έννοιες ανάλογα με το πλαίσιο στο οποίο χρησιμοποιείται. Στη βιολογία, ορίζεται ως το αναπαραγωγικό μέρος ενός φυτού που βλασταίνει για να αναπτυχθεί, για παράδειγμα. Επομένως, ένα μικρόβιο είναι μεταφορικά γνωστό ως εκκινητής, όπως μια κίνηση.
Σε αυτό το άρθρο, θα ρίξουμε μια πιο προσεκτική ματιά στο τι είναι τα μικρόβια και πού βρίσκονται. Συνεχίστε να διαβάζετε εάν θέλετε να μάθετε περισσότερα για αυτόν τον συναρπαστικό μικροσκοπικό κόσμο!
Τι είναι τα μικρόβια;
Ορίζουμε αυτόν τον όρο ως οποιονδήποτε μικροοργανισμό ικανό να προκαλέσει ασθένεια ή να καταστρέψει τον ξενιστή του, είτε ζωικής ή φυτικής προέλευσης. Συνολικά, υπάρχουν τέσσερις κύριοι τύποι μικροβίων που θα αναλύσουμε παρακάτω.
Θέλετε να μάθετε περισσότερα; Διαβάστε: 3 θεραπευτικά smoothies για το σύνδρομο ευερέθιστου εντέρου
Βακτήρια
Τα βακτήρια είναι προκαρυωτικοί (δηλαδή μονοκύτταροι) οργανισμοί, οι οποίοι έχουν μέγεθος λίγων χιλιοστών και έχουν διάφορα σχήματα.
Σύμφωνα με το Earth Microbiome Project, εκτιμούν ότι υπάρχουν περισσότερα από ένα τρισεκατομμύριο είδη βακτηρίων στον πλανήτη, οπότε δεν υπερβάλλουμε όταν λέμε ότι είναι το βασικό θεμέλιο κάθε οικοσυστήματος. Ανάλογα με τη μορφολογία τους, μπορούν να χωριστούν σε διάφορους τύπους:
- Οι κόκκοι έχουν σφαιρικό σχήμα και εξαρτώνται από τον αριθμό των ατόμων που απαρτίζουν τη δομή τους (διπλόκοκκοι, τετράκοκκοι και στρεπτόκοκκοι).
- Τα βακίλια έχουν σχήμα ράβδου.
- Οι ελικοειδείς μορφές είναι οι σπείρες και οι σπιροχέτες.
Τα βακτήρια μπορεί να είναι ακίνητα ή να έχουν κινητικές ικανότητες, είτε μέσω βλεφαρίδας είτε μαστιγίου που τους βοηθούν να κινηθούν. Ανάλογα με τη μέθοδο ανίχνευσής τους, με βάση τη φύση του εξωτερικού τοιχώματος της δομής τους, μπορεί να είναι αρνητικά κατά gram ή θετικά κατά gram. Αυτοί οι μικροοργανισμοί μπορεί να είναι ελεύθεροι ζωντανοί ή παθογόνοι οργανισμοί ζωντανών όντων, συμπεριλαμβανομένων των ανθρώπων.
Σύμφωνα με τον αυστηρό ορισμό του όρου, μόνο τα βακτήρια που προκαλούν ασθένειες θεωρούνται μικρόβια.

Ιός
Οι ιοί είναι ακόμη μικρότεροι από τα βακτήρια και απλούστεροι από τα βακτήρια. Αυτά τα μικρόβια αποτελούνται από αλυσίδες DNA ή RNA (μεμονωμένες ή πολλαπλές από αυτές) που καλύπτονται από ένα στρώμα πρωτεΐνης που τους δίνει το τρισδιάστατο σχήμα τους.
Οι επιστήμονες έχουν περιγράψει περίπου 5.000 είδη ιών, και δεν μπορούν να αναπαραχθούν χωρίς έναν ξενιστή. Οι ιοί λεηλατούν τα κύτταρα του ασθενούς και οι μηχανισμοί τους, αυτοαντιγραφούνται για να συνεχίσουν να διαδίδουν την ασθένεια στον πληθυσμό.
Δείτε αυτό το άρθρο: 5 πράγματα που πρέπει να γνωρίζετε για τα αυτοάνοσα νοσήματα
Μύκητες, πρωτόζωα και άλλα
Προκειμένου να διατηρηθεί αυτός ο χώρος όσο το δυνατόν πιο περιεκτικός και ενημερωτικός, θα συνοψίσουμε τα υπόλοιπα μικρόβια ή παθογόνα παρακάτω:
- Τα πρωτόζωα είναι μονοκύτταροι μικροοργανισμοί όπως τα βακτήρια, αλλά διαφέρουν από αυτά λόγω του μεγαλύτερου μεγέθους και της μορφολογικής τους πολυπλοκότητας. Ζουν σε υγρά περιβάλλοντα και μπορεί να είναι παράσιτα ή να ζουν ελεύθερα. Ένα πολύ σαφές παράδειγμα είναι το πρωτόζωο που προκαλεί ελονοσία.
- Οι μύκητες, σε αντίθεση με αυτούς που αναφέρθηκαν στο προηγούμενο σημείο, είναι μια ταξινόμηση σύνθετων πολυκυτταρικών οργανισμών, μεταξύ των οποίων είναι η μούχλα, η μαγιά και παραγωγοί μανιταριών. Μερικοί μύκητες μπορούν να μολύνουν τόσο ζώα όσο και φυτά, σχηματίζοντας μυκήλιο στους προσβεβλημένους ιστούς και τρέφοντάς τους.
- Υπάρχουν επίσης άλλα μικρόβια που είναι πιο δύσκολο να περιγραφούν, όπως ιοειδή ή πρίον. Αυτά είναι μόρια RNA που μπορούν να μολύνουν ζώα ή φυτά.
Πού μπορείτε να βρείτε τα περισσότερα μικρόβια;
Το καλύτερο ερώτημα θα ήταν ποιο μέρος της γης είναι απαλλαγμένο από αυτά. Οι μικροοργανισμοί κυριαρχούν σε όλα τα περιβάλλοντα και μας περιβάλλουν ανά πάσα στιγμή (και βρίσκονται ακόμη και μέσα μας!).
Όμως, επειδή με την αυστηρή έννοια της λέξης ένα μικρόβιο είναι παθογόνο για άλλα ζωντανά όντα, είναι σημαντικό να μιλάμε για την επικράτησή τους σε συγκεκριμένους δημόσιους χώρους:
- Πισίνες και υδάτινα πάρκα. Εδώ όλα ενώνονται. Τα πρωτόζωα και οι μύκητες απαιτούν υγρασία και οι ιοί χρειάζονται υψηλή πυκνότητα ξενιστή. Οποιοδήποτε υγρό και γεμάτο μέρος είναι ένα καλό σημείο αναπαραγωγής για τις αποικίες των μικροβίων.
- Χρήματα, καρότσια σούπερ μάρκετ, επιφάνειες σε δημόσιους χώρους τουαλέτας κ.λπ. Πολλοί ιοί και βακτήρια παραμένουν στις επιφάνειες για ένα ορισμένο χρονικό διάστημα, οπότε όσο περισσότερα άτομα έρχονται σε επαφή με ένα αντικείμενο, τόσο πιθανότερο είναι αποκτήσουν το μικρόβιο.
- Το ίδιο το ανθρώπινο σώμα. Αν και μπορεί να φαίνεται εκπληκτικό, ένα έως δύο κιλά (2-4 κιλά) του σωματικού μας βάρους προέρχεται από βακτήρια, τα οποία υπάρχουν κυρίως στην εντερική μας οδό. Ναι, αυτά δεν εμπίπτουν στον ορισμό του μικροβίου, καθώς δεν είναι παθογόνα για εμάς. Παρόλα αυτά, ο άνθρωπος παρουσιάζει υψηλό ιικό φορτίο όταν πάσχει από ασθένεια, όπως η γρίπη ή τα κρυολογήματα.
Όπως είδαμε, ο ορισμός των μικροβίων είναι μικρός όταν πρόκειται για την κάλυψη των πολλαπλών μικροοργανισμών που δημιουργούν ασθένειες στα έμβια όντα. Ωστόσο, όλοι έχουν κάτι κοινό: Είναι μικροσκοπικά όντα που εκμεταλλεύονται την ύπαρξη άλλων για να επιβιώσουν, προκαλώντας διάφορες ασθένειες στους ξενιστές τους.
Όλες οι παραθέτονται πηγές ελέγχθηκαν προσεκτικά από την ομάδα μας για να διασφαλιστεί η ποιότητα, η αξιοπιστία, η επικαιρότητα και η εγκυρότητά τους. Η βιβλιογραφία αυτού του άρθρου θεωρήθηκε αξιόπιστη και επιστημονικά ακριβής.
- Broniatowski DA, Klein EY, Reyna VF. Germs are germs, and why not take a risk? Patients’ expectations for prescribing antibiotics in an inner-city emergency department. Med Decis Making. 2015;35(1):60‐67. doi:10.1177/0272989X14553472
-
National Research Council (US) Committee to Update Science, Medicine, and Animals. Science, Medicine, and Animals. Washington (DC): National Academies Press (US); 2004. A Theory of Germs. Available from: https://www.ncbi.nlm.nih.gov/books/NBK24649/
-
InformedHealth.org [Internet]. Cologne, Germany: Institute for Quality and Efficiency in Health Care (IQWiG); 2006-. What are microbes? 2010 Oct 6 [Updated 2019 Aug 29]. Available from: https://www.ncbi.nlm.nih.gov/books/NBK279387/
Αυτό το κείμενο προσφέρεται μόνο για ενημερωτικούς σκοπούς και δεν αντικαθιστά τη συμβουλή από επαγγελματία. Σε περίπτωση αμφιβολίας, συμβουλευτείτε τον ειδικό σας.







